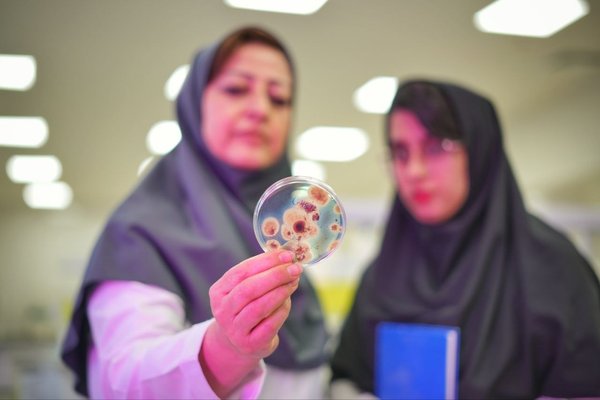
Technology-Based Bio/Organic Fertilizers and Biopesticides-img

Mega Projects

Propagation, Sanitization and Production of Healthy Primary Nucleuses of Horticultural Plant

Producing Hybrid Seeds for Vegetables Using Modern Genetic Modification Technologies (Doubled Haploid and Reverse Breeding)
Technology-Based Production of Food Supplements and Nutritional Additives
Technology-Based Bio/Organic Fertilizers and Biopesticides

Advanced Technological Production of Nano Fertilizers and Nano Pesticides

Production Engineering and Refinery of Medicinal Plants

Molecular Breeding

Climate-Adapted Plants to Supply Food for Humans and Animals in Climate Change Conditions

Development and Utilization of Emerging Technologies in Agriculture

Development of Transgenic/Genome Edited Crops
